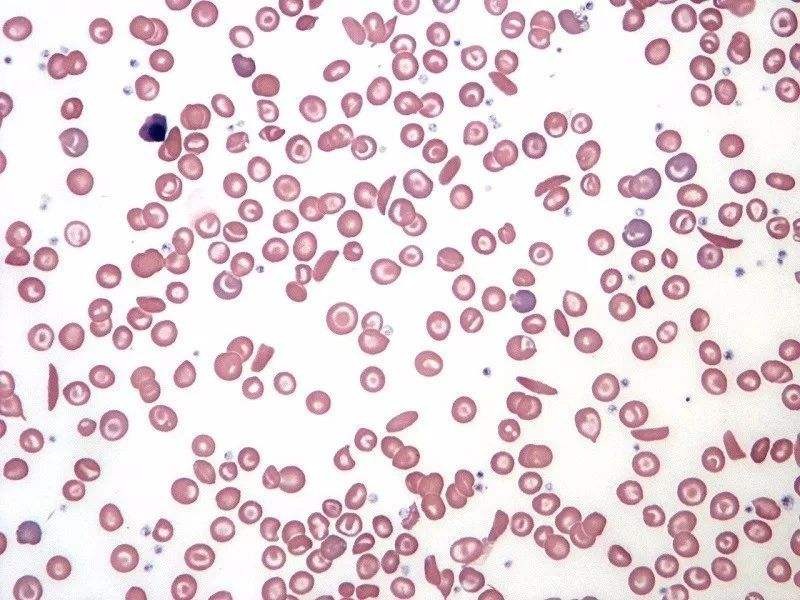

粉体行业在线展览
CELL PAT
面议
晶格码
CELL PAT
4847
细胞培养过程在线监测实例
(在线显微镜与细胞计数仪数据对比)

与细胞计数仪对比
细胞培养过程在线监测实例
(在线拉曼与生化分析仪数据对比)
葡萄糖浓度

乳酸浓度

谷氨酸浓度

谷氨酰胺浓度
本系统是以原位显微镜和在线拉曼光谱仪作为 PAT 工具,对细胞生长过程的细胞形态、大小、密度和细胞营养物质及代谢产物(五个生化指标:葡萄糖、乳酸、谷氨酸、谷氨酰胺、铵离子)浓度进行实时在线检测和分析。原位显微镜实时拍摄细胞图像,实时得到细胞的直径分布,并估算细胞密度。通过在线拉曼光谱仪实时获取体系的拉曼光谱,建立光谱数据与生化指标浓度的多元校正模型,实时分析细胞培养过程中的生化指标浓度。
结果表明,原位显微镜的结果与细胞计数仪结果有良好的拟合性;拉曼光谱数据与生化指标浓度建立的多元校正模型能够实时预测生化指标的浓度。
这两种 PAT 工具可以在线检测并分析细胞生长状态,可以提高细胞生存环境的质量,从而使生物药的产品质量提高。
Intelligent Crystallization Platform
Nano Sonic
3D Stereovision NI
Stereovision Crystal G3
Turbidity Probe
SHAPE
Crystal MPB
JGM ATR FTIR
JGM RAMAN
CELL PAT
2D Vision Probe
JGM NIR
TH-F120
BL-GHX-VK
A500
线性压电纳米位移台MF40-25A
InSight 软包电池透射X射线衍射仪
ParticleX TC
SuperSEM N10
SLS-LED-80B
Lyza 3000
在线浊度计
SCI300